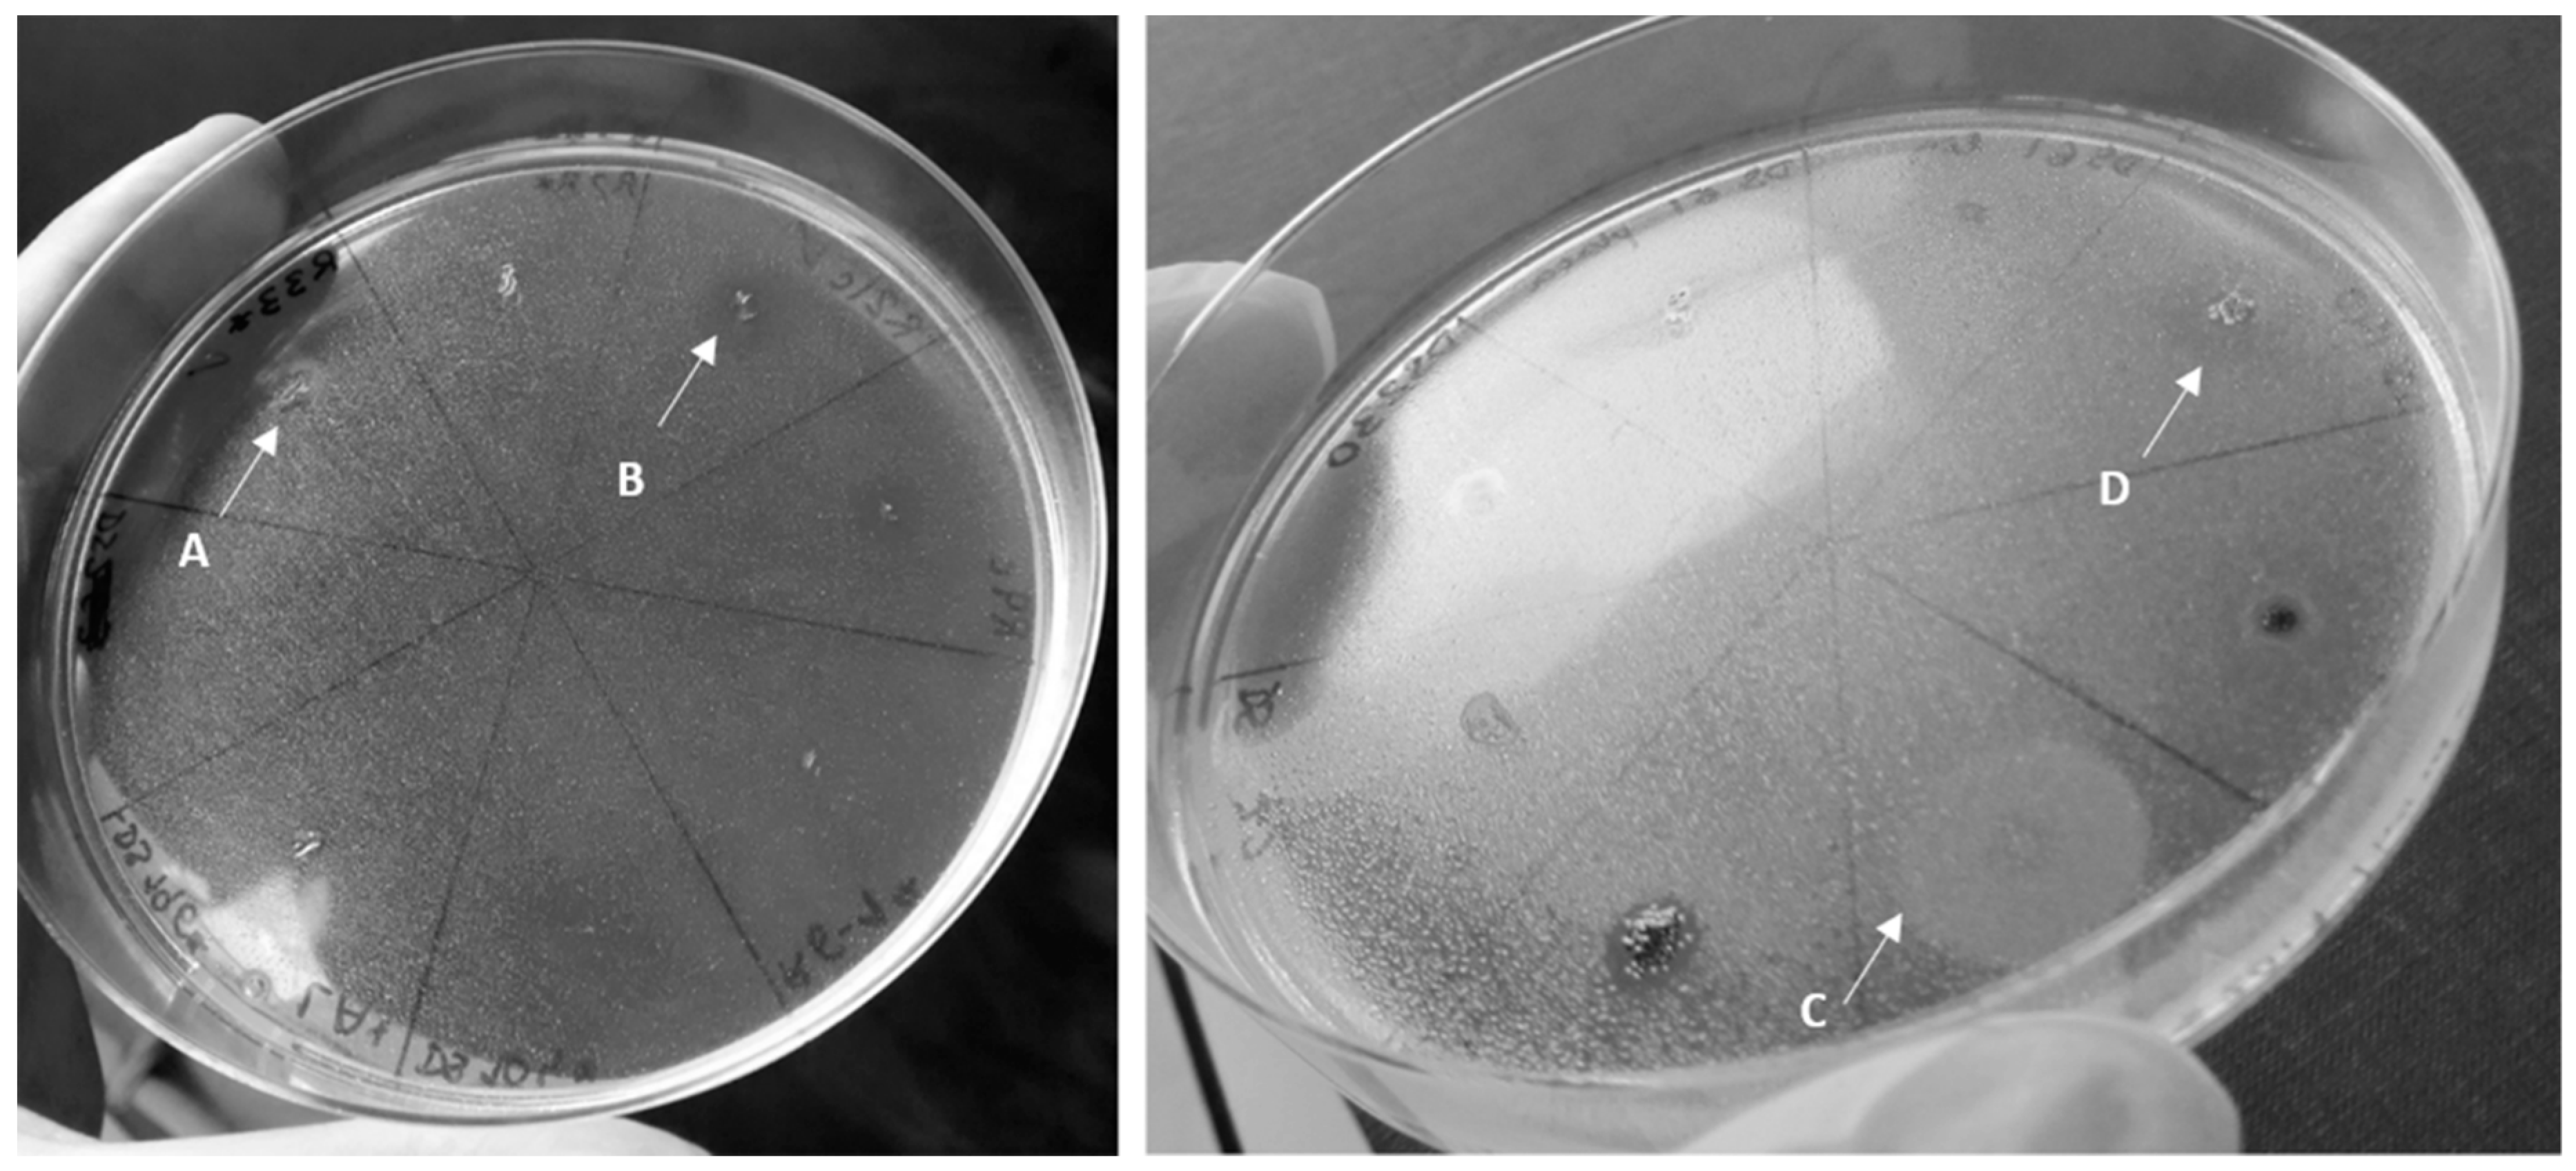
Ijerph 17 01746 g002 Ijerph 17 01746 g002

Biosurfactant Production in Sub-Oxic Conditions Detected in Hydrocarbon-Degrading Isolates from Marine and Estuarine Sediments
Abstract
1. Introduction
2. Materials and Methods
2.1. Sediment Sampling
2.2. Anaerobic Selective Cultures—General Procedure
2.2.1. Selective Cultures of Estuarine Sediments
2.2.2. Selective Cultures of Deep-Sea Sediments
2.3. Isolation, Purification and Identification of Bacterial Strains
2.4. Analysis of Biosurfactant Production
3. Results and Discussion
3.1. Isolation and Identification of Isolates
3.2. Biosurfactant Production
3.2.1. Effect of Oxygen Availability
3.2.2. Effect of Culture Medium in Biosurfactant Production
3.2.3. Biosurfactant Production in Estuarine and Deep-Sea Bacterial Isolates: Biotechnological Potential
4. Conclusions
Author Contributions
Funding
Acknowledgments
Conflicts of Interest
References
- Marchant, R.; Banat, I.M. Biosurfactants: A sustainable replacement for chemical surfactants? Biotechnol. Lett. 2012, 34, 1597–1605. [Google Scholar] [CrossRef] [PubMed]
- Ron, E.Z.; Rosenberg, E. Natural roles of biosurfactants. Environ. Microbiol. 2001, 3, 229–236. [Google Scholar] [CrossRef] [PubMed]
- Elliot, R.; Singhal, N.; Swift, S. Surfactants and bacterial bioremediation of polycyclic aromatic hydrocarbon contaminated soil—Unlocking the targets. Crit. Rev. Environ. Sci. Technol. 2010, 41, 78–124. [Google Scholar] [CrossRef]
- Zhao, X.; Gong, Y.; O’Reilly, S.E.; Zhao, D. Effects of oil dispersant on solubilization, sorption and desorption of polycyclic aromatic hydrocarbons in sediment-seawater systems. Mar. Pollut. Bull. 2015, 92, 160–169. [Google Scholar] [CrossRef] [PubMed]
- Baruah, R.; Kalita, D.J.; Saikia, B.K.; Gautam, A.; Singh, A.K.; Deka Boruah, H.P. Native hydrocarbonoclastic bacteria and hydrocarbon mineralization processes. Int. Biodeterior. Biodegrad. 2016, 112, 18–30. [Google Scholar] [CrossRef]
- Singh, A.; Van Hamme, J.D.; Ward, O.P. Surfactants in microbiology and biotechnology: Part 2. Application aspects. Biotechnol. Adv. 2007, 25, 99–121. [Google Scholar] [CrossRef]
- Pinzon, N.M.; Cook, A.G.; Ju, L.-K. Continuous rhamnolipid production using denitrifying Pseudomonas aeruginosa cells in hollow-fiber bioreactor. Biotechnol. Prog. 2013, 29, 352–358. [Google Scholar] [CrossRef]
- Domingues, P.M.; Almeida, A.; Leal, L.S.; Gomes, N.C.; Cunha, Â. Bacterial production of biosurfactants under microaerobic and anaerobic conditions. Rev. Environ. Sci. BioTechnol. 2017, 16, 239–272. [Google Scholar] [CrossRef]
- Schneiker, S.; dos Santos, V.A.M.; Bartels, D.; Bekel, T.; Brecht, M.; Buhrmester, J.; Chernikova, T.N.; Denaro, R.; Ferrer, M.; Gertler, C.; et al. Genome sequence of the ubiquitous hydrocarbon-degrading marine bacterium Alcanivorax borkumensis. Nat. Biotechnol. 2006, 24, 997–1004. [Google Scholar] [CrossRef]
- Rojo, F. Degradation of alkanes by bacteria. Environ. Microbiol. 2009, 11, 2477–2490. [Google Scholar] [CrossRef]
- Gutierrez, T.; Green, D.H.; Nichols, P.D.; Whitman, W.B.; Semple, K.T.; Aitken, M.D. Polycyclovorans algicola gen. nov., sp. nov., an aromatic-hydrocarbon-degrading marine bacterium found associated with laboratory cultures of marine phytoplankton. Appl. Environ. Microbiol. 2013, 79, 205–214. [Google Scholar] [CrossRef]
- Yakimov, M.M.; Timmis, K.N.; Golyshin, P.N. Obligate oil-degrading marine bacteria. Curr. Opin. Biotechnol. 2007, 18, 257–266. [Google Scholar] [CrossRef] [PubMed]
- Stauffert, M.; Cravo-Laureau, C.; Duran, R. Structure of hydrocarbonoclastic nitrate-reducing bacterial communities in bioturbated coastal marine sediments. FEMS Microbiol. Ecol. 2014, 89, 580–593. [Google Scholar] [CrossRef] [PubMed]
- Acosta-González, A.; Marqués, S. Bacterial diversity in oil-polluted marine coastal sediments. Curr. Opin. Biotechnol. 2016, 38, 24–32. [Google Scholar] [CrossRef]
- Aitken, C.M.; Jones, D.M.; Larter, S.R. Anaerobic hydrocarbon biodegradation in deep subsurface oil reservoirs. Nature 2004, 431, 291–294. [Google Scholar] [CrossRef] [PubMed]
- Bose, A.; Rogers, D.R.; Adams, M.M.; Joye, S.B.; Girguis, P.R. Geomicrobiological linkages between short-chain alkane consumption and sulfate reduction rates in seep sediments. Front. Microbiol. 2013, 4, 386. [Google Scholar] [CrossRef] [PubMed]
- Kleindienst, S.; Herbst, F.-A.; Stagars, M.; von Netzer, F.; von Bergen, M.; Seifert, J.; Peplies, J.; Amann, R.; Musat, F.; Lueders, T.; et al. Diverse sulfate-reducing bacteria of the Desulfosarcina/Desulfococcus clade are the key alkane degraders at marine seeps. ISME J. 2014, 8, 2029–2044. [Google Scholar] [CrossRef]
- Alonso-Gutierrez, J.; Figueras, A.; Albaiges, J.; Jimenez, N.; Vinas, M.; Solanas, A.M.; Novoa, B. Bacterial communities from shoreline environments (Costa da Morte, northwestern Spain) affected by the Prestige oil spill. Appl. Environ. Microbiol. 2009, 75, 3407–3418. [Google Scholar] [CrossRef]
- Rothermich, M.M.; Hayes, L.A.; Lovley, D.R. Anaerobic, sulfate-dependent degradation of polycyclic aromatic hydrocarbons in petroleum-contaminated harbor sediment. Environ. Sci. Technol. 2002, 36, 4811–4817. [Google Scholar] [CrossRef]
- Kim, S.J.; Park, S.J.; Cha, I.T.; Min, D.; Kim, J.S.; Chung, W.H.; Chae, J.C.; Jeon, C.O.; Rhee, S.K. Metabolic versatility of toluene-degrading, iron-reducing bacteria in tidal flat sediment, characterized by stable isotope probing-based metagenomic analysis. Environ. Microbiol. 2014, 16, 189–204. [Google Scholar] [CrossRef]
- Lomstein, B.A.; Langerhuus, A.T.; D’Hondt, S.; Jørgensen, B.B.; Spivack, A.J. Endospore abundance, microbial growth and necromass turnover in deep sub-seafloor sediment. Nature 2012, 484, 101–104. [Google Scholar] [CrossRef]
- Bernardino, A.F.; Levin, L.A.; Thurber, A.R.; Smith, C.R. Comparative composition, diversity and trophic ecology of sediment macrofauna at vents, seeps and organic falls. PLoS ONE 2012, 7, e33515. [Google Scholar] [CrossRef]
- Boetius, A.; Wenzhöfer, F.; Wenzhofer, F. Seafloor oxygen consumption fuelled by methane from cold seeps. Nat. Geosci. 2013, 6, 725–734. [Google Scholar] [CrossRef]
- Levin, L.A. Ecology of cold seep sediments: Interactions of fauna with flow, chemistry and microbes. In Oceanography and Marine Biology: An Annual Review, 1st ed.; Gibson, R.N., Atkinson, R.J.A., Gordon, J.D.M., Eds.; CRC Press: Boca Raton, FL, USA, 2005; Volume 43, pp. 1–46. [Google Scholar]
- Glud, R.N. Oxygen dynamics of marine sediments. Mar. Biol. Res. 2008, 4, 243–289. [Google Scholar] [CrossRef]
- Parinos, C.; Gogou, A.; Bouloubassi, I.; Pedrosa-Pàmies, R.; Hatzianestis, I.; Sanchez-Vidal, A.; Rousakis, G.; Velaoras, D.; Krokos, G.; Lykousis, V. Occurrence, sources and transport pathways of natural and anthropogenic hydrocarbons in deep-sea sediments of the eastern Mediterranean Sea. Biogeosciences 2013, 10, 6069–6089. [Google Scholar] [CrossRef]
- Louvado, A.; Gomes, N.C.M.; Simões, M.M.Q.; Almeida, A.; Cleary, D.F.R.; Cunha, A. Polycyclic aromatic hydrocarbons in deep sea sediments: Microbe-pollutant interactions in a remote environment. Sci. Total Environ. 2015, 526, 312–328. [Google Scholar] [CrossRef] [PubMed]
- Mason, O.U.; Scott, N.M.; Gonzalez, A.; Robbins-Pianka, A.; Bælum, J.; Kimbrel, J.; Bouskill, N.J.; Prestat, E.; Borglin, S.; Joyner, D.C.; et al. Metagenomics reveals sediment microbial community response to Deepwater Horizon oil spill. ISME J. 2014, 8, 1464–1475. [Google Scholar] [CrossRef] [PubMed]
- Kimes, N.E.; Callaghan, A.V.; Aktas, D.F.; Smith, W.L.; Sunner, J.; Golding, B.; Drozdowska, M.; Hazen, T.C.; Suflita, J.M.; Morris, P.J. Metagenomic analysis and metabolite profiling of deep-sea sediments from the Gulf of Mexico following the Deepwater Horizon oil spill. Front. Microbiol. 2013, 4, 50. [Google Scholar] [CrossRef] [PubMed]
- Hazen, T.C.; Dubinsky, E.A.; DeSantis, T.Z.; Andersen, G.L.; Piceno, Y.M.; Singh, N.; Jansson, J.K.; Probst, A.; Borglin, S.E.; Fortney, J.L.; et al. Deep-sea oil plume enriches indigenous oil-degrading bacteria. Science 2010, 330, 204–208. [Google Scholar] [CrossRef] [PubMed]
- Nercessian, O.; Fouquet, Y.; Pierre, C.; Prieur, D.; Jeanthon, C. Diversity of Bacteria and Archaea associated with a carbonate-rich metalliferous sediment sample from the Rainbow vent field on the Mid-Atlantic Ridge. Environ. Microbiol. 2005, 7, 698–714. [Google Scholar] [CrossRef] [PubMed]
- Gregg, T.; Prahl, F.G.; Simoneit, B.R.T. Suspended particulate matter transport of polycyclic aromatic hydrocarbons in the lower Columbia River and its estuary. Limnol. Oceanogr. 2015, 60, 1935–1949. [Google Scholar] [CrossRef]
- Pintado-Herrera, M.G.; Wang, C.; Lu, J.; Chang, Y.-P.; Chen, W.; Li, X.; Lara-Martín, P.A. Distribution, mass inventories, and ecological risk assessment of legacy and emerging contaminants in sediments from the Pearl River Estuary in China. J. Hazard. Mater. 2017, 323, 128–138. [Google Scholar] [CrossRef] [PubMed]
- McGenity, T.J. Hydrocarbon biodegradation in intertidal wetland sediments. Curr. Opin. Biotechnol. 2014, 27, 46–54. [Google Scholar] [CrossRef] [PubMed]
- LaRiviere, D.J.; Autenrieth, R.L.; Bonner, J.S. Redox dynamics during recovery of an oil-impacted estuarine wetland. Water Res. 2003, 37, 3307–3318. [Google Scholar] [CrossRef]
- Zaikowski, L.; McDonnell, K.T.; Rockwell, R.F.; Rispoli, F. Temporal and spatial variations in water quality on New York south shore estuary tributaries: Carmans, Patchogue, and Swan rivers. Estuaries Coasts 2008, 31, 85–100. [Google Scholar] [CrossRef]
- McKew, B.A.; Coulon, F.; Osborn, A.M.; Timmis, K.N.; McGenity, T.J. Determining the identity and roles of oil-metabolizing marine bacteria from the Thames estuary, UK. Environ. Microbiol. 2007, 9, 165–176. [Google Scholar] [CrossRef]
- Domingues, P.M.; Louvado, A.; Oliveira, V.; Coelho, F.J.C.R.; Almeida, A.; Gomes, N.C.M.; Cunha, A. Selective cultures for the isolation of biosurfactant producing bacteria: Comparison of different combinations of environmental inocula and hydrophobic carbon sources. Prep. Biochem. Biotechnol. 2013, 43, 237–255. [Google Scholar] [CrossRef]
- Sanni, G.O.; Coulon, F.; McGenity, T.J. Dynamics and distribution of bacterial and archaeal communities in oil-contaminated temperate coastal mudflat mesocosms. Environ. Sci. Pollut. Res. 2015, 22, 15230–15247. [Google Scholar] [CrossRef]
- Oliveira, V.; Gomes, N.C.M.; Cleary, D.F.R.; Almeida, A.; Silva, A.M.S.; Simões, M.M.Q.; Silva, H.; Cunha, Â. Halophyte plant colonization as a driver of the composition of bacterial communities in salt marshes chronically exposed to oil hydrocarbons. FEMS Microbiol. Ecol. 2014, 90, 647–662. [Google Scholar] [CrossRef]
- Hensen, C. TransFlux—Tracing for Active Dewatering Sites along Deep-Reaching Transform Faults in the Western Gulf of Cadiz; Cruise No. M86/5—February 23–March 16 2012—Palma de Mallorca (Spain)–Lisbon (Portugal); DFG—Senatskommission für Ozeanographie: Bremen, Germany, 2014. [Google Scholar]
- Plugge, C.M. Anoxic media design, preparation, and considerations. In Methods in Enzymology; Jared, R.L., Ed.; Academic Press: Cambridge, MA, USA, 2005; Volume 397, pp. 3–16. [Google Scholar]
- Wolfe, R.S. Techniques for cultivating methanogens. In Methods in Enzymology; Amy, C.R., Stephen, W.R., Eds.; Academic Press: Cambridge, MA, USA, 2011; Volume 494, pp. 1–22. [Google Scholar]
- Widdel, F. Cultivation of anaerobic microorganisms with hydrocarbons as growth substrates. In Handbook of Hydrocarbon and Lipid Microbiology; Timmis, K.N., Ed.; Springer: Berlin/Heidelberg, Germany, 2010; pp. 3787–3798. [Google Scholar]
- Henriques, I.S.; Almeida, A.; Cunha, Â.; Correia, A. Molecular sequence analysis of prokaryotic diversity in the middle and outer sections of the Portuguese estuary Ria de Aveiro. FEMS Microbiol. Ecol. 2004, 49, 269–279. [Google Scholar] [CrossRef]
- Rademaker, J.; Louws, F.; Versalovic, J.; Bruijn, F.; Kowalchuk, G.; Head, I.; Akkermans, A.; Elsas, J. Section 3 update: Characterization of the diversity of ecologically important microbes by rep-PCR genomic fingerprinting. In Molecular Microbial Ecology Manual; Kowalchuk, G.A., de Bruijn, F.J., Head, I.M., Akkermans, A.D., van Elsas, J.D., Eds.; Springer: Dordrecht, The Netherlands, 2008; pp. 2513–2545. [Google Scholar]
- Weisburg, W.G.; Barns, S.M.; Pelletier, D.A.; Lane, D.J. 16S ribosomal DNA amplification for phylogenetic study. J. Bacteriol. 1991, 173, 697–703. [Google Scholar] [CrossRef]
- Burch, A.Y.; Shimada, B.K.; Browne, P.J.; Lindow, S.E. Novel high-throughput detection method to assess bacterial surfactant production. Appl. Environ. Microbiol. 2010, 76, 5363–5372. [Google Scholar] [CrossRef] [PubMed]
- Déziel, E.; Lépine, F.; Milot, S.; Villemur, R. rhlA is required for the production of a novel biosurfactant promoting swarming motility in Pseudomonas aeruginosa: 3-(3-hydroxyalkanoyloxy)alkanoic acids (HAAs), the precursors of rhamnolipids. Microbiology 2003, 149, 2005–2013. [Google Scholar] [CrossRef] [PubMed]
- Plaza, G.A.; Zjawiony, I.; Banat, I.M. Use of different methods for detection of thermophilic biosurfactant-producing bacteria from hydrocarbon-contaminated and bioremediated soils. J. Pet. Sci. Eng. 2006, 50, 71–77. [Google Scholar] [CrossRef]
- Satpute, S.K.; Banpurkar, A.G.; Dhakephalkar, P.K.; Banat, I.M.; Chopade, B.A. Methods for investigating biosurfactants and bioemulsifiers: A review. Crit. Rev. Biotechnol. 2010, 30, 127–144. [Google Scholar] [CrossRef] [PubMed]
- Pereira, J.F.B.; Gudiña, E.J.; Costa, R.; Vitorino, R.; Teixeira, J.A.; Coutinho, J.A.P.; Rodrigues, L.R. Optimization and characterization of biosurfactant production by Bacillus subtilis isolates towards microbial enhanced oil recovery applications. Fuel 2013, 111, 259–268. [Google Scholar] [CrossRef]
- Louvado, A.; Coelho, F.J.R.C.; Domingues, P.; Santos, A.L.; Gomes, N.C.M.; Almeida, A.; Cunha, Â. Isolation of surfactant-resistant pseudomonads from the estuarine surface microlayer. J. Microbiol. Biotechnol. 2012, 22, 283–291. [Google Scholar] [CrossRef]
- Wang, W.; Cai, B.; Shao, Z. Oil degradation and biosurfactant production by the deep sea bacterium Dietzia maris As-13-3. Front. Microbiol. 2014, 5, 711. [Google Scholar] [CrossRef]
- Wu, Y.; He, T.; Zhong, M.; Zhang, Y.; Li, E.; Huang, T.; Hu, Z. Isolation of marine benzo[a]pyrene-degrading Ochrobactrum sp. BAP5 and proteins characterization. J. Environ. Sci. 2009, 21, 1446–1451. [Google Scholar] [CrossRef]
- Joy, S.; Rahman, P.K.S.M.; Sharma, S. Biosurfactant production and concomitant hydrocarbon degradation potentials of bacteria isolated from extreme and hydrocarbon contaminated environments. Chem. Eng. J. 2017, 317, 232–241. [Google Scholar] [CrossRef]
- Doi, Y.; Takaya, N.; Takizawa, N. Novel denitrifying bacterium Ochrobactrum anthropi YD50.2 tolerates high levels of reactive nitrogen oxides. Appl. Environ. Microbiol. 2009, 75, 5186–5194. [Google Scholar] [CrossRef] [PubMed][Green Version]
- Sipahutar, M.K.; Vangnai, A.S. Role of plant growth-promoting Ochrobactrum sp. MC22 on triclocarban degradation and toxicity mitigation to legume plants. J. Hazard. Mater. 2017, 329, 38–48. [Google Scholar] [CrossRef] [PubMed]
- Gregory, L.G.; Bond, P.L.; Richardson, D.J.; Spiro, S. Characterization of a nitrate-respiring bacterial community using the nitrate reductase gene (narG) as a functional marker. Microbiology 2003, 149, 229–237. [Google Scholar] [CrossRef] [PubMed]
- Liao, V.H.C.; Chu, Y.J.; Su, Y.C.; Hsiao, S.Y.; Wei, C.C.; Liu, C.W.; Liao, C.M.; Shen, W.C.; Chang, F.J. Arsenite-oxidizing and arsenate-reducing bacteria associated with arsenic-rich groundwater in Taiwan. J. Contam. Hydrol. 2011, 123, 20–29. [Google Scholar] [CrossRef]
- Bonin, P.; Vieira, C.; Grimaud, R.; Militon, C.; Cuny, P.; Lima, O.; Guasco, S.; Brussaard, C.P.D.; Michotey, V. Substrates specialization in lipid compounds and hydrocarbons of Marinobacter genus. Environ. Sci. Pollut. Res. 2015, 22, 15347–15359. [Google Scholar] [CrossRef] [PubMed]
- Patowary, K.; Saikia, R.R.; Kalita, M.C.; Deka, S. Degradation of polyaromatic hydrocarbons employing biosurfactant-producing Bacillus pumilus KS2. Ann. Microbiol. 2015, 65, 225–234. [Google Scholar] [CrossRef]
- Gutiérrez, A.M.; Cabriales, J.J.P.; Vega, M.M. Isolation and characterization of hexavalent chromium-reducing rhizospheric bacteria from a wetland. Int. J. Phytoremediation 2010, 12, 317–334. [Google Scholar] [CrossRef]
- Ghosh, S.; Sar, P. Identification and characterization of metabolic properties of bacterial populations recovered from arsenic contaminated ground water of North East India (Assam). Water Res. 2013, 47, 6992–7005. [Google Scholar] [CrossRef]
- Chang, Y.T.; Chou, H.L.; Chao, H.P.; Chang, Y.J. The influence of sorption on polyaromatic hydrocarbon biodegradation in the presence of modified nonionic surfactant organoclays. Int. Biodeterior. Biodegrad. 2015, 102, 237–244. [Google Scholar] [CrossRef]
- Ubani, O.; Atagana, H.I.; Thantsha, M.S.; Rasheed, A. Identification and characterisation of oil sludge degrading bacteria isolated from compost. Arch. Environ. Prot. 2016, 42, 67–77. [Google Scholar] [CrossRef]
- Bacosa, H.P.; Thyng, K.M.; Plunkett, S.; Erdner, D.L.; Liu, Z. The tarballs on Texas beaches following the 2014 Texas City “Y” Spill: Modeling, chemical, and microbiological studies. Mar. Pollut. Bull. 2016, 109, 236–244. [Google Scholar] [CrossRef] [PubMed]
- Naeem, A.H.; Mumtaz, S.; Haleem, A.; Qazi, M.A.; Malik, Z.A.; Dasti, J.I.; Ahmed, S. Isolation and molecular characterization of biosurfactant-producing bacterial diversity of Fimkassar oil field, Pakistan. Arab. J. Sci. Eng. 2017, 42, 2349–2359. [Google Scholar] [CrossRef]
- Padmavathi, A.R.; Pandian, S.K. Antibiofilm activity of biosurfactant producing coral associated bacteria isolated from Gulf of Mannar. Indian J. Microbiol. 2014, 54, 376–382. [Google Scholar] [CrossRef] [PubMed]
- Mani, P.; Dineshkumar, G.; Jayaseelan, T.; Deepalakshmi, K.; Ganesh Kumar, C.; Senthil Balan, S. Antimicrobial activities of a promising glycolipid biosurfactant from a novel marine Staphylococcus saprophyticus SBPS 15. 3 Biotech 2016, 6, 1–9. [Google Scholar] [CrossRef]
- Nakano, M.; Iehata, S.; Tanaka, R.; Maeda, H. Extracellular neutral lipids produced by the marine bacteria Marinobacter sp. Biocontrol Sci. 2012, 17, 69–75. [Google Scholar] [CrossRef] [PubMed]
- Dong, H.; Zhang, Z.Z.; He, Y.L.; Luo, Y.J.; Xia, W.J.; Sun, S.S.; Zhang, G.Q.; Zhang, Z.Y.; Gao, D.L. Biostimulation of biogas producing microcosm for enhancing oil recovery in low-permeability oil reservoir. RSC Adv. 2015, 5, 91869–91877. [Google Scholar] [CrossRef]
- Rajaei, S.; Seyedi, S.M.; Raiesi, F.; Shiran, B.; Raheb, J. Characterization and potentials of indigenous oil-degrading bacteria inhabiting the rhizosphere of wild oat (Avena fatua L.) in south west of Iran. Iran. J. Biotechnol. 2013, 11, 32–40. [Google Scholar] [CrossRef]
- Oliveira, V.; Gomes, N.C.M.; Almeida, A.; Silva, A.M.S.; Simões, M.M.Q.; Smalla, K.; Cunha, Â. Hydrocarbon contamination and plant species determine the phylogenetic and functional diversity of endophytic degrading bacteria. Mol. Ecol. 2014, 23, 1392–1404. [Google Scholar] [CrossRef]
- De Cruzeiro, S.M.A. Isolation and Characterization of Halophilic Bacteria from Salt Pans of Ria de Aveiro. Master’s Thesis, University of Aveiro, Aveiro, Portugal, 2018. [Google Scholar]
- Domingues, P.M. Subaquatic Sediments as Sources of Hydrocarbonoclastic and Biosurfactant Producing Facultative Anaerobic Bacteria. Ph.D. Thesis, University of Aveiro, Aveiro, Portugal, 2018. [Google Scholar]
- Fichtel, K.; Mathes, F.; Könneke, M.; Cypionka, H.; Engelen, B. Isolation of sulfate-reducing bacteria from sediments above the deep-subseafloor aquifer. Front. Microbiol. 2012, 3, 65. [Google Scholar] [CrossRef]
- Tapilatu, Y.; Acquaviva, M.; Guigue, C.; Miralles, G.; Bertrand, J.C.; Cuny, P. Isolation of alkane-degrading bacteria from deep-sea Mediterranean sediments. Lett. Appl. Microbiol. 2010, 50, 234–236. [Google Scholar] [CrossRef]
- Tsubouchi, T.; Koyama, S.; Mori, K.; Shimane, Y.; Usui, K.; Tokuda, M.; Tame, A.; Uematsu, K.; Maruyama, T.; Hatada, Y. Brevundimonas denitrificans sp. nov., a denitrifying bacterium isolated from deep subseafloor sediment. Int. J. Syst. Evol. Microbiol. 2014, 64, 3709–3716. [Google Scholar] [CrossRef] [PubMed]
- Zhang, Y.; Su, X.; Chen, F.; Wang, Y.; Jiao, L.; Dong, H.; Huang, Y.; Jiang, H. Microbial diversity in cold seep sediments from the northern South China Sea. Geosci. Front. 2012, 3, 301–316. [Google Scholar] [CrossRef]
- Ettoumi, B.; Chouchane, H.; Guesmi, A.; Mahjoubi, M.; Brusetti, L.; Neifar, M.; Borin, S.; Daffonchio, D.; Cherif, A. Diversity, ecological distribution and biotechnological potential of Actinobacteria inhabiting seamounts and non-seamounts in the Tyrrhenian Sea. Microbiol. Res. 2016, 186, 71–80. [Google Scholar] [CrossRef]
- Batista, S.B.; Mounteer, A.H.; Amorim, F.R.; Tótola, M.R. Isolation and characterization of biosurfactant/bioemulsifier-producing bacteria from petroleum contaminated sites. Bioresour. Technol. 2006, 97, 868–875. [Google Scholar] [CrossRef] [PubMed]
- Karanth, N.G.K.; Deo, P.G.; Veenanadig, N.K. Microbial production of biosurfactants and their importance. Curr. Sci. 1999, 77, 116–126. [Google Scholar]
- González-Cabaleiro, R.; Ofiţeru, I.D.; Lema, J.M.; Rodríguez, J. Microbial catabolic activities are naturally selected by metabolic energy harvest rate. ISME J. 2015, 9, 2630–2641. [Google Scholar] [CrossRef] [PubMed]
- Guez, J.S.; Müller, C.H.; Danze, P.M.; Büchs, J.; Jacques, P. Respiration activity monitoring system (RAMOS), an efficient tool to study the influence of the oxygen transfer rate on the synthesis of lipopeptide by Bacillus subtilis ATCC6633. J. Biotechnol. 2008, 134, 121–126. [Google Scholar] [CrossRef]
- Wenjie, X.; Li, Y.; Ping, W.; Jianlong, X.; Hanping, D. Characterization of a thermophilic and halotolerant Geobacillus pallidus H9 and its application in microbial enhanced oil recovery (MEOR). Ann. Microbiol. 2012, 62, 1779–1789. [Google Scholar] [CrossRef]
- Zhao, F.; Mandlaa, M.; Hao, J.; Liang, X.; Shi, R.; Han, S.; Zhang, Y. Optimization of culture medium for anaerobic production of rhamnolipid by recombinant Pseudomonas stutzeri Rhl for microbial enhanced oil recovery. Lett. Appl. Microbiol. 2014, 59, 231–237. [Google Scholar] [CrossRef]

| Station | Latitude (D:M) | Longitude (W) | Depth (m) | Activity |
|---|---|---|---|---|
| 329 | 35:44.34 | 10:12.06 | 4492 | Active |
| 348 | 35:44.41 | 10:12.18 | 4497 | Inactive |
| Supplements | Fermentative | SRB | NRB | Solid MSM |
|---|---|---|---|---|
| 0.5 M Na2SO4 (mL L−1) | - | 28 | - | 28 |
| 0.5 M KNO3 (mL L−1) | - | - | 40 | 40 |
| 0.2 M Na2S 9H2O (mL L−1) | 5 | 5 | - | - |
| 0.2 M Cysteine-HCl (mL L−1) | 15 | 15 | - | - |
| 0.5 M Ascorbic acid (mL L−1) | - | - | 8 | 8 |
| Agarose (g L−1) | - | - | - | 20 |
| Crude oil (% v/v) | 1 | 1 | 1 | 50 µL a |
| Selective Pressure | ||||
|---|---|---|---|---|
| NRB | SRB | Fermentative | ||
| Inocula | Abiotic control | Ø -NRB | Ø -SRB | Ø -Fer |
| Mud | M-NRB | M-SRB | M-Fer | |
| Sand | S-NRB | S-SRB | S-Fer | |
| Selective Pressure (Added Electron Acceptors) | ||||||||
|---|---|---|---|---|---|---|---|---|
| Without Crude | With Crude | |||||||
| None | NO3− | SO4−2 | NO3− + SO4−2 | None | NO3− | SO4−2 | NO3− + SO4−2 | |
| Na2SO4 (g L−1) | 0.5 a | 0.5 a | 4.0 | 4.0 | 0.5 a | 0.5 a | 4.0 | 4.0 |
| KNO3 (g L−1) | - | 1.0 | - | 1.0 | - | 1.0 | - | 1.0 |
| Reducing agent Na2S · 9H2O (g L−1) | - | - | 0.24 | 0.24 | - | - | 0.24 | 0.24 |
| Inoculum (mL L−1) | 100 | 100 | 100 | 100 | 100 | 100 | 100 | 100 |
| Crude oil (mL L−1) | - | - | - | - | 44.4 | 44.4 | 44.4 | 44.4 |
| Selective Pressure | |||||||||
|---|---|---|---|---|---|---|---|---|---|
| Without Crude | With Crude | ||||||||
| None | NO3− | SO4−2 | NO3− + SO4−2 | None | NO3− | SO4−2 | NO3− + SO4−2 | ||
| Inocula | Abiotic control | Ø-0 | Ø-N | Ø-S | Ø-NS | Ø-C | Ø-NC | Ø-SC | Ø-NSC |
| Active MV | A-0 | A-N | A-S | A-NS | A-C | A-NC | A-SC | A-NSC | |
| Inactive MV | I-0 | I-N | I-S | I-NS | I-C | I-NC | I-SC | I-NSC | |
| Isolate No. | Selective Culture | Sequence Accession No. | Closest Relative | ||
|---|---|---|---|---|---|
| BLAST-N Identity | Accession No. | % Identity | |||
| DS27 | Ab-0 | MF490026 | Pseudomonas sp. | KR088605 | 99 |
| DS61 | Ia-N | MF490027 | Bacillus subtilis | KU862331 | 100 |
| DS72 | Ic-S | MF490028 | Brevundimonas sp. | LN833256 | 100 |
| DS104 | Ib-NS | MF490029 | Psychrobacter sp. | KF859544 | 100 |
| DS140 | Ic-C | MF490030 | Staphylococcus sp. | KT282233 | 99 |
| DS192 | Ic-NC | MF490031 | Pseudomonas sp. | KX301316 | 100 |
| R21 | S-Met | MF490033 | Marinobacter salsuginis | KM041132 | 99 |
| R33 | S-SRB | MF490034 | Curtobacterium flaccumfaciens | KF003415 | 100 |
| R47 | M-SRB | MF490035 | Pseudomonas xanthomarina | KY465430 | 99 |
| R53 | M-NRB | MF490036 | Pseudomonas sp. | LN877946 | 99 |
| R98 | M-NRB | MF490037 | Ochrobactrum sp. | KJ676969 | 100 |
| R114 | S-SRB | MF490038 | Ochrobactrum sp. | JQ014582 | 100 |
| Isolates | Atomized Oil Assay (Halo Diameter in cm) | Surface Tension Reduction * (mN/m) | Emulsification Index E24 (%) | |||||
|---|---|---|---|---|---|---|---|---|
| LA Aer. | LA Anaer. | MA Aer. | MA Anaer. | Aer. | Anaer. | Aer. | Anaer. | |
| DS27 | 0.6 ± 0.21 a | 0.0 ± 0.00 b | 0.4 ± 0.21 a | 0.0 ± 0.00 b | 3.3 ± 2.51 | 1.4 ± 0.97 | 2.5 ± 0.14 | 0.0 ± 0.00 |
| DS61 | 0.6 ± 0.16 a | 0.3 ± 0.07 a | 0.6 ± 0.15 a | 0.8 ± 0.39 a | 2.0 ± 0.89 | 3.9 ± 6.97 | 3.5 ± 0.19 | 7.8 ± 6.34 |
| DS72 | 0.4 ± 0.04 a | 0.5 ± 0.44 a | 0.4 ± 0.04 a,b | 0.0 ± 0.00 b | 1.9 ± 1.68 | 1.6 ± 2.56 | 0.0 ± 0.00 | 5.2 ± 4.53 |
| DS104 | 0.7 ± 0.23 a | 0.3 ± 0.04 b | 0.5 ± 0.22 a,b | 0.5 ± 0.22 a,b | 1.9 ± 2.80 | 1.2 ± 2.08 | 60.6 ± 9.32 | 7.3 ± 3.43 |
| DS140 | 0.9 ± 0.31 a | 1.3 ± 0.45 b | 0.6 ± 0.15 a | 1.0 ± 0.49 a,b | −1.4 ± 2.11 | −1.7 ± 4.16 | 7.1 ± 0.85 | 2.9 ± 0.79 |
| DS192 | 0.7 ± 0.30 a | 0.3 ± 0.16 a,b | 0.5 ± 0.17 a,b | 0.1 ± 0.04 b | −0.3 ± 0.97 | 1.5 ± 3.11 | 8.2 ± 1.21 | 13.5 ± 4.84 |
| R21 | 1.3 ± 0.39 a | 0.5 ± 0.24 b | 0.6 ± 0.24 b | 0.2 ± 0.11 b | 1.4 ± 2.96 | −0.2 ± 3.92 | 12.3 ± 10.27 | 6.3 ± 3.84 |
| R33 | 0.6 ± 0.12 a | 0.1 ± 0.10 b | 0.6 ± 0.23 a | 0.2 ± 0.15 b | 7.1 ± 1.65 | 0.6 ± 3.75 | 38.6 ± 13.50 | 8.0 ± 3.36 |
| R47 | 1.1 ± 0.40 a | 0.5 ± 0.13 b | 0.4 ± 0.29 b | 0.3 ± 0.11 b | 9.9 ± 0.37 | 4.5 ± 3.57 | 61.2 ± 6.41 | 0.0 ± 0.00 |
| R53 | 0.7 ± 0.09 a | 0.5 ± 0.32 a | 0.3 ± 0.13 a | 0.4 ± 0.13 a | 5.3 ± 1.64 | 2.0 ± 0.55 | 44.7 ± 5.83 | 35.0 ± 9.31 |
| R98 | 0.5 ± 0.16 a,c | 0.0 ± 0.00 b | 0.8 ± 0.39 a | 0.3 ± 0.22 b,c | 6.3 ± 2.76 | 2.1 ± 0.64 | 10.3 ± 6.84 | 6.7 ±4.33 |
| R114 | 0.6 ± 0.15 a | 0.3 ± 0.22 a | 0.7 ± 0.18 a | 0.3 ± 0.31 a | 6.7 ± 3.16 | 0.7 ± 1.09 | 13.1 ± 5.27 | 18.0 ± 11.32 |
| E. coli DH5α | 0.0 ± 0.00 a | 0.0 ± 0.00 a | 0.0 ± 0.00 a | 0.0 ± 0.00 a | - | - | - | - |
| Pseudomonas sp. 74 | 1.2 ± 0.35 a | 0.8 ± 0.58 a,b | 1.0 ± 0.57 a,b | 0.7 ± 0.47 b | - | - | - | - |
© 2020 by the authors. Licensee MDPI, Basel, Switzerland. This article is an open access article distributed under the terms and conditions of the Creative Commons Attribution (CC BY) license (http://creativecommons.org/licenses/by/4.0/).
Share and Cite
Domingues, P.M.; Oliveira, V.; Serafim, L.S.; Gomes, N.C.M.; Cunha, Â. Biosurfactant Production in Sub-Oxic Conditions Detected in Hydrocarbon-Degrading Isolates from Marine and Estuarine Sediments. Int. J. Environ. Res. Public Health 2020, 17, 1746. https://doi.org/10.3390/ijerph17051746
Domingues PM, Oliveira V, Serafim LS, Gomes NCM, Cunha Â. Biosurfactant Production in Sub-Oxic Conditions Detected in Hydrocarbon-Degrading Isolates from Marine and Estuarine Sediments. International Journal of Environmental Research and Public Health. 2020; 17(5):1746. https://doi.org/10.3390/ijerph17051746
Chicago/Turabian StyleDomingues, Patrícia M., Vanessa Oliveira, Luísa Seuanes Serafim, Newton C. M. Gomes, and Ângela Cunha. 2020. "Biosurfactant Production in Sub-Oxic Conditions Detected in Hydrocarbon-Degrading Isolates from Marine and Estuarine Sediments" International Journal of Environmental Research and Public Health 17, no. 5: 1746. https://doi.org/10.3390/ijerph17051746
APA StyleDomingues, P. M., Oliveira, V., Serafim, L. S., Gomes, N. C. M., & Cunha, Â. (2020). Biosurfactant Production in Sub-Oxic Conditions Detected in Hydrocarbon-Degrading Isolates from Marine and Estuarine Sediments. International Journal of Environmental Research and Public Health, 17(5), 1746. https://doi.org/10.3390/ijerph17051746

